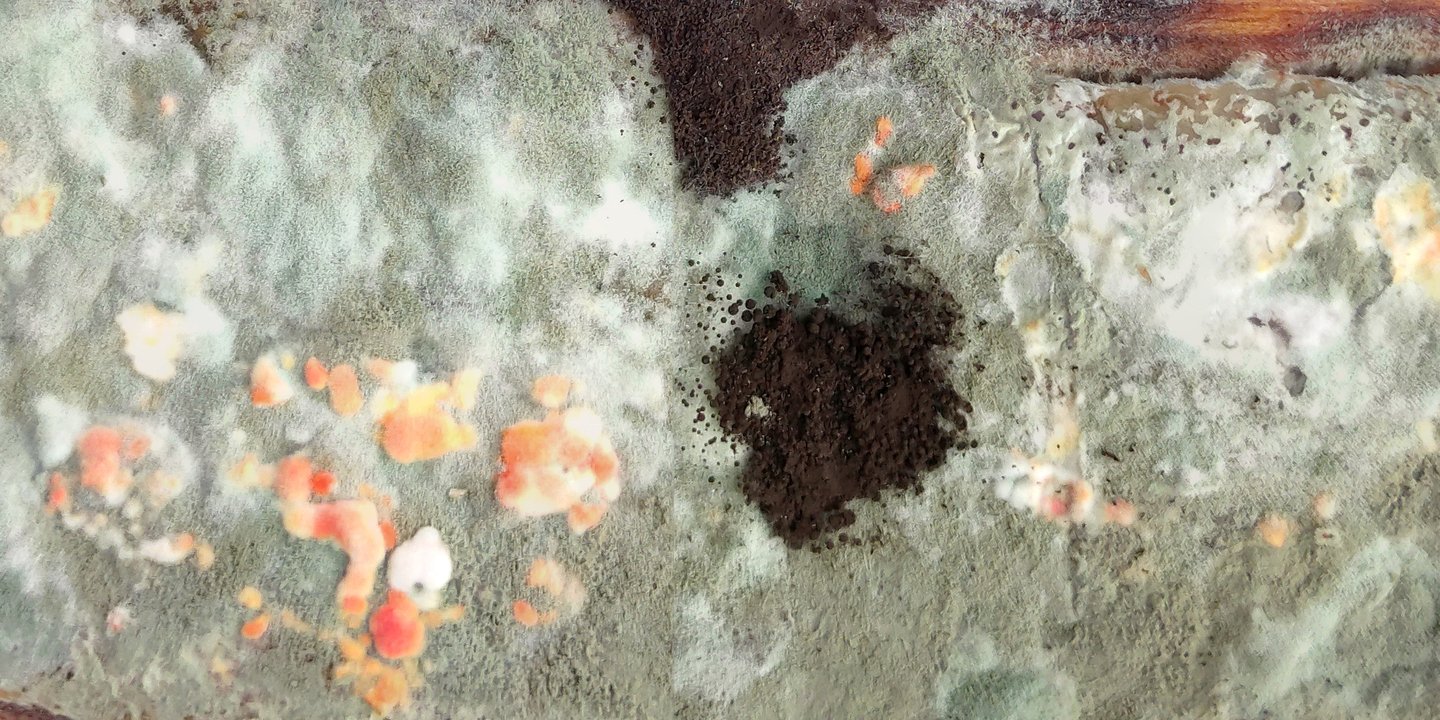
big

Иногда инопланетные пейзажи ближе чем кажется
Я всегда видел камеру как инструмент увидит новое, без значения если это на другом конце мира, на другой планете или на одной руки расстояния. В своей серии «Фантастические пейзажи» передаю свое видение, что удивительные и красивые вещи не надо искать в неком далеком, неизведанном месте, а нужно увидеть их рядом. Они всегда есть.

Откуда эти пейзажи?
Идея для эксперимента пришла когда я на некоторые время забыл кусок яблоки и увидел насколько красиво может быть гниение фруктов и овощей. Поэтому запечатлел разные этапы процесса, который длился две недели.